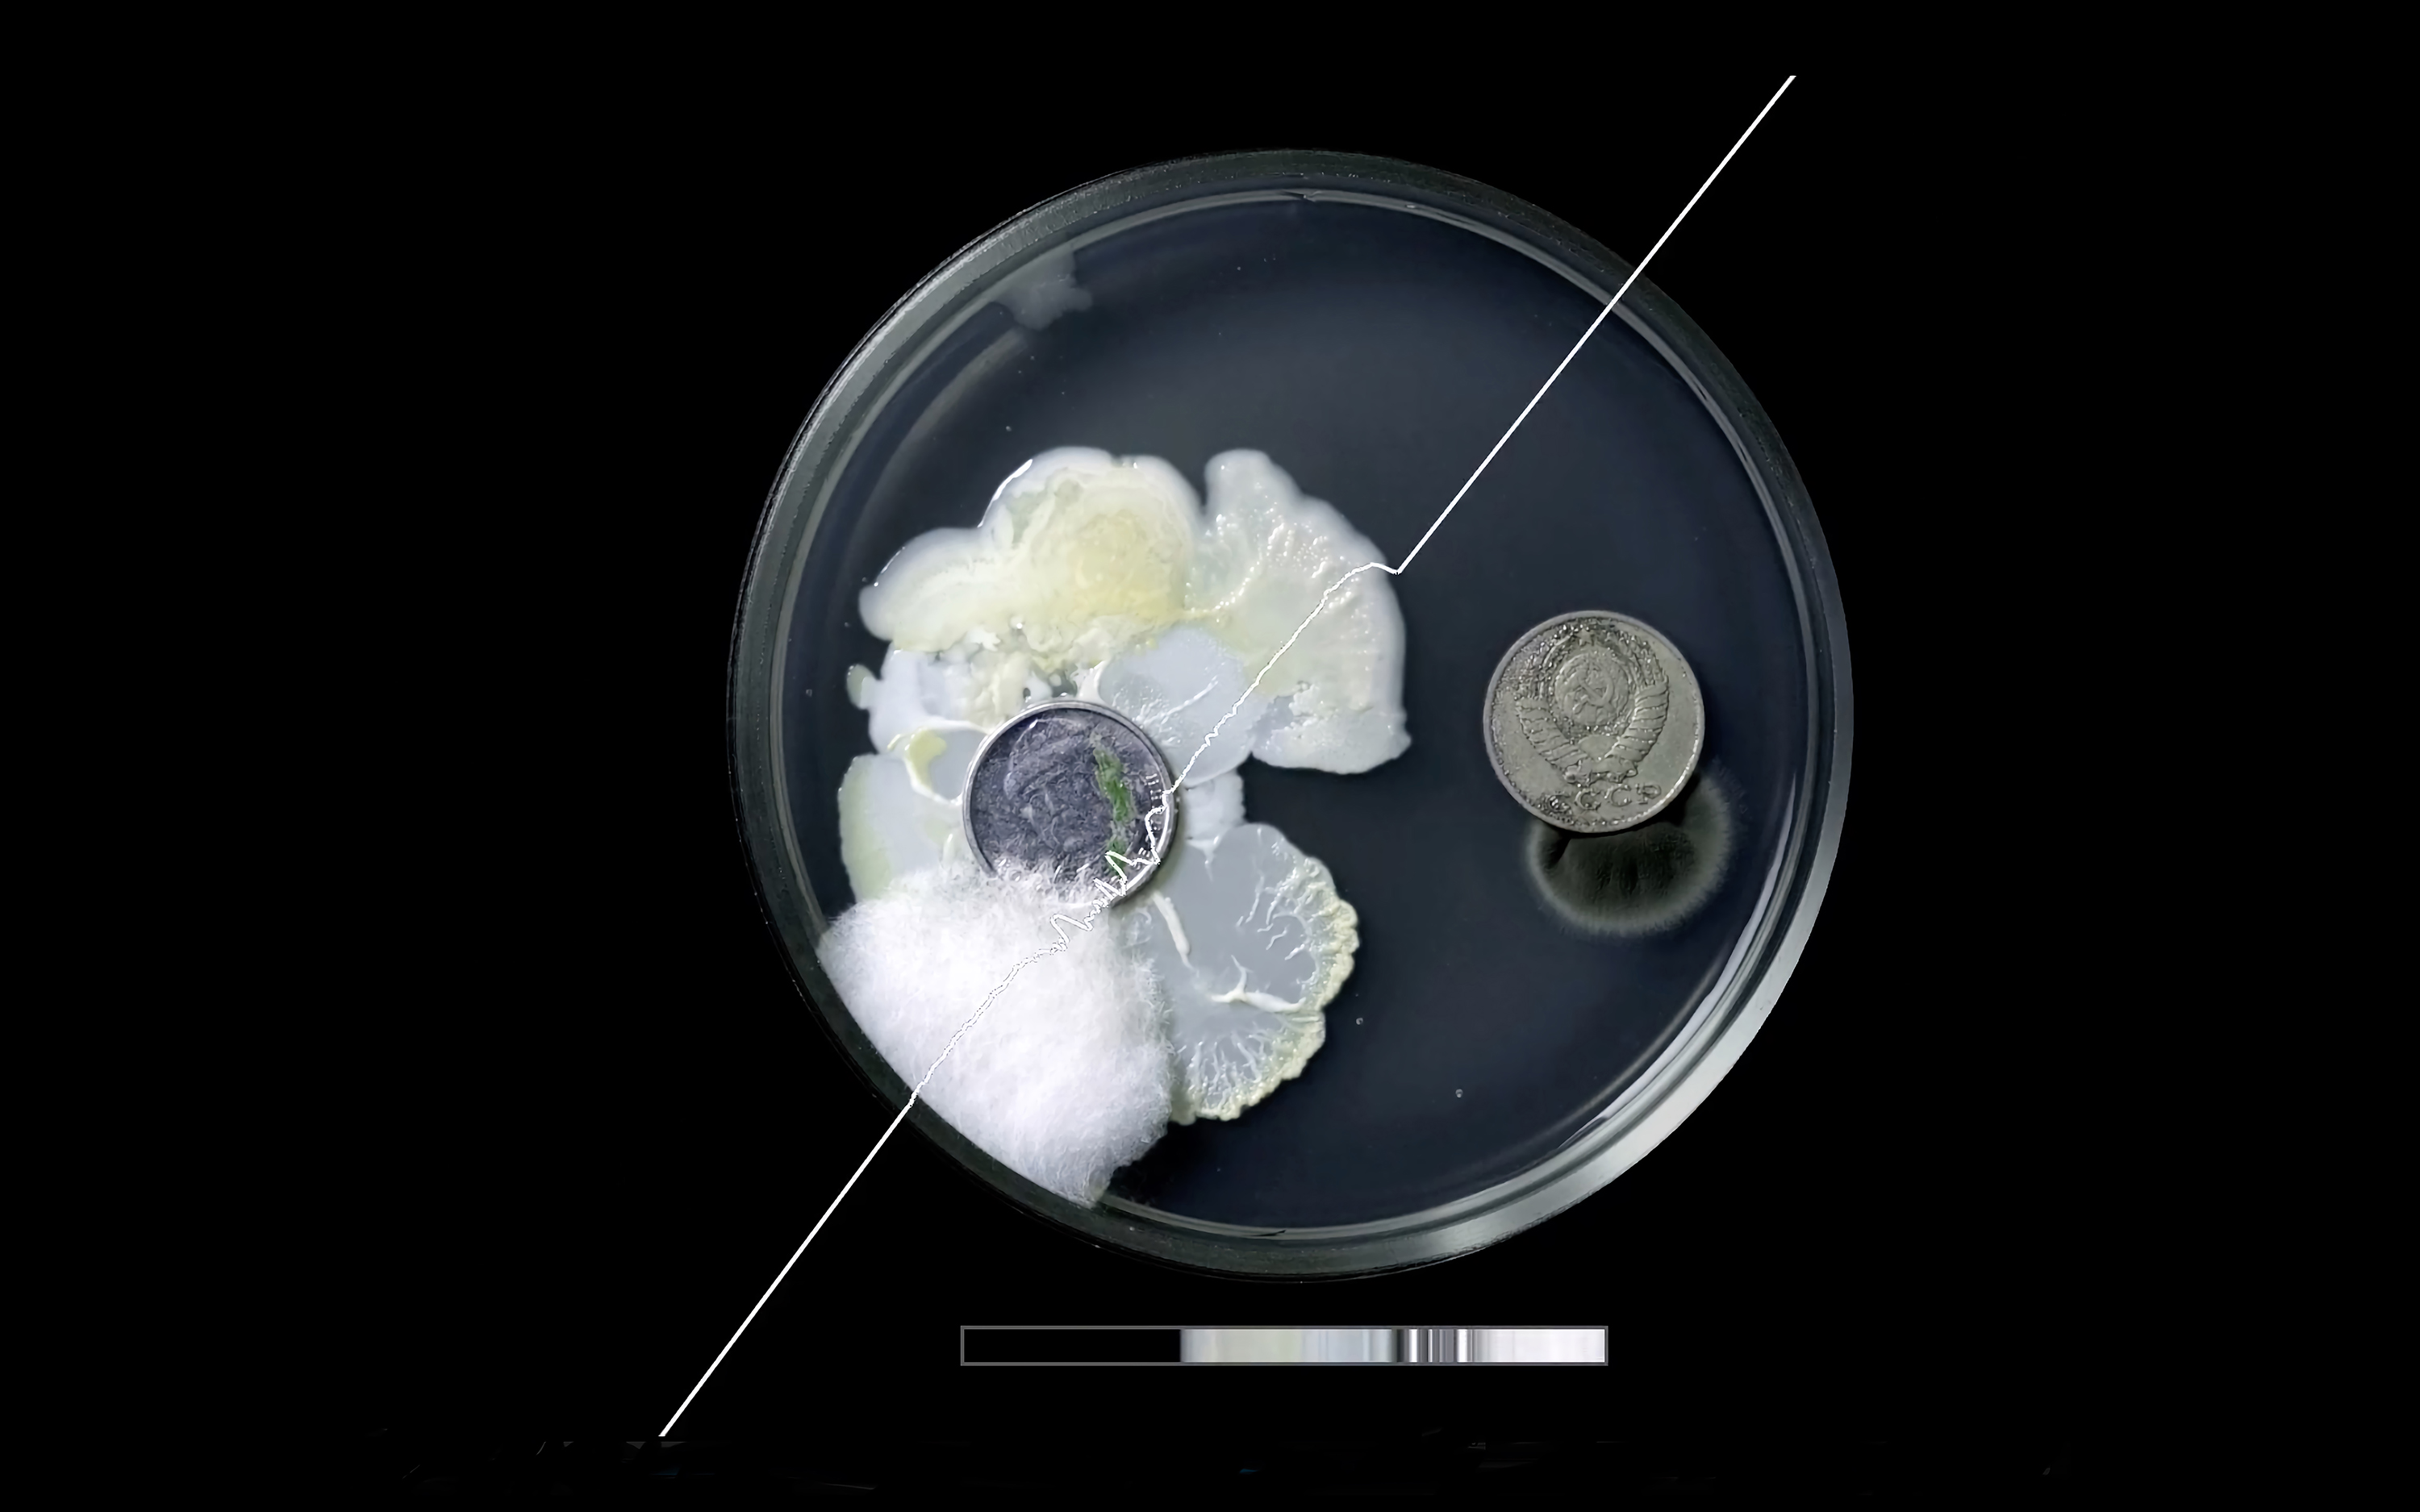

Изложбата "Докато стоиш до мен" е с международно участие и ще бъде открита на 26 април 2022 г. в "Бял куб" – галерията на РЦСИ "Топлоцентрала" с резидентен куратор Владия Михайлова. Изложбата поставя началото на програмата на визуалните изкуства в центъра. “Докато стоиш до мен” се развива в духа на настоящото време и събития и ще остане в "Топлоцентрала" до 25 май 2022 г.
Художниците са призовани от куратора Владия Михайлова да споделят до какво или до кого биха застанали самите те в знак на подкрепа и равнопоставеност. Ценности, стоящи в основата и на идеята, и на институцията "Топлоцентрала", която е пространство за свободната сцена за съвременни изкуства.
Участват Валентина Шарра, Невена Екимова, Нилбар Гюреш, Камен Стоянов и Антони Райжеков заедно с украинските художници – Анастасия Прозора, Анастасия Съсенко, Антон Лапов, Костянтън Зоркин, Хръстъна Силивон, Мъхайло Барабаш, Остап Мануляк, Роман Гайдейчук, Серхий Петлюк, Серхий Коровяцькъй, B_ST_FFORT aka ∿undeleted, Ujif_notfound.
Днес повече отвсякога сме призовани да подкрепяме идеи и ценности, разкази и истини, разни хоризонти на бъдеще. Подкрепяме не само с думи, но и с дела. Заставаме с телата си до принципи и хора и те образуват територии, редици и множества, граници и барикади, окопи и шествия. Подкрепата е присъствие, конкретна дистанция, физическо и ментално общо поле, избор и грижа.
"Да застанеш до нещо или някого в негово име, с решителност и лоялност, е предизвикателство, което художниците в изложбата осъществяват в широкия спектър от личното до универсалното и от родното до световното. Тяхното споделяне е свързано с близостта в човешкото общуване и връзката със семейството (Невена Екимова); с оживяването на бели петна в колективната памет, търсенето на възможна алтернативна история и обществен порядък отвъд властта (Камен Стоянов); с категоричността на художествения жест и човешката емпатия, призоваващи за справедливост (Нилбар Гюреш), с услието за създаване на универсална граматика на символите на мира (Валентина Шарра) и с решителността на действието да приемеш други хора в твоето пространство, заставайки заедно с тях на общия фронт на човешкия живот и смисъл (Антони Райжеков).
По инициатива на Антони Райжеков в изложбата са поканени да участват със свои видеа деветима украински художници, част от които в момента са доброволци в различни дейности на фронта в Украйна, а някои от тях са и участници в преките бойни действия. Съвместната работа на автора с тях започва още през 2021 г. във връзка с произведението му "Дует в самоопределение", което представлява коментар за влиянието и амбициите на постсъветска Русия върху страните от Източна Европа. В настоящата изложба работата на Райжеков се превръща в общо поле заедно с видео творби на художниците от Украйна" – споделя Владия Михайлова, куратор на "Бял куб".
На 26 април от 20:00 ч. ще се проведе пърформансът "Не докосвай пода" на Невена Екимова. „Както всяка игра, и тази е много по-забавна, когато не си играеш сам“ – казва тя.
На снимките:
1. Невена Екимова, "Не докосвай пода", 2010, 2022, пърформанс
2. Антони Райжеков, "Дует в самоопределение", 2021, 2022, кадър от видео
3. Камен Стоянов, "Перманентната революция на Георги Константинов", 2022, док. филм

4. Валентина Шарра, "Формула 1", 2022, скулптура

